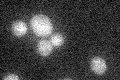
YMR199W
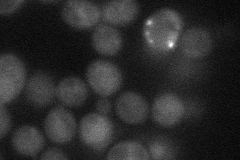
YMR199W
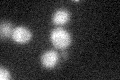
YMR199W

View description
G1 cyclin involved in regulation of the cell cycle; activates Cdc28p kinase to promote the G1 to S phase transition; late G1 specific expression depends on transcription factor complexes, MBF (Swi6p-Mbp1p) and SBF (Swi6p-Swi4p)
Localization:
Intensity:
Fold change:
Significance:
-
C’ GFP library in SD
below threshold18.63 -
N' NOP1pr-GFP in SD
cytosol21.6108 -
N' TEF2pr-mCherry in SD

nucleus5.0398 -
N' NATIVEpr-GFP in SD

cytosol23.2983 -
N' TEF2pr-VC and Cyto-VN in SD

#N/A0 -
C’ GFP library in SD+DTT

cytosol16.470.88No -
C’ GFP library in SD+H2O2
cytosol19.151.02No -
C’ GFP library in Starvation Media

cytosol15.410.82No -
C’ GFP library on the background of Pup2-DaMP

below threshold -
C’ GFP library on the background of CCT mutant

below threshold19.20861.03074No
